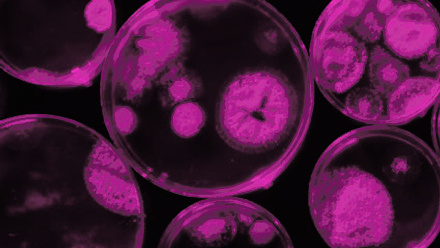
Access-Micro-news-425x500px.jpg

Fee-free Open Access publishing in Microbiology Society titles for developing and transition economy countries and territories: new agreement signed with EIFL
Facilitating a smooth OA publishing experience, corresponding authors from eligible countries or territories will automatically be offered the applicable fee waiver.
Britt-Marie Wideberg, EIFL Licensing Programme Manager: “We are very pleased to have closed an agreement with Microbiology Society. This new agreement will support researchers and authors in 33 EIFL countries and give them the opportunity to publish without any costs. This will also increase the number of articles published OA."
Peter Cotgreave, Chief Executive of the Microbiology Society: “Championing the research of our international community is a crucial part of our strategy at the Microbiology Society. We are delighted to be working with EIFL to support even more microbiologists across the globe with simple OA publishing to increase visibility of their work.”
This agreement will cover the Microbiology Society’s entire portfolio of hybrid and fully OA journals: Access Microbiology, International Journal of Systematic and Evolutionary Microbiology, Journal of General Virology, Journal of Medical Microbiology, Microbial Genomics and Microbiology.
Eligible countries and territories under EIFL
About the Microbiology Society
The Microbiology Society is a membership charity for scientists interested in microbes, their effects, and their practical uses. It has a worldwide membership based in universities, industry, hospitals, research institutes, schools, and other organisations. Find out more at microbiologysociety.org.
Contact: Sarah Cooper, Journals Marketing and Development Lead, Microbiology Society – s.cooper@microbiologysociety.org
About EIFL
EIFL (Electronic Information for Libraries) is a not-for-profit organisation that works with libraries to enable access to knowledge in developing and transition economy countries in Africa, Asia Pacific, Europe and Latin America. EIFL runs a number of programmes to enable access to knowledge for education, learning, research and sustainable community development. This includes negotiating agreements with publishers to secure affordable access to e-resources as well as Open Access publishing terms on behalf of libraries and authors in EIFL partner countries. Find out more at eifl.net.
Contact: Britt-Marie Wideberg, Licensing Programme Manager, EIFL – britt-marie.wideberg@eifl.net